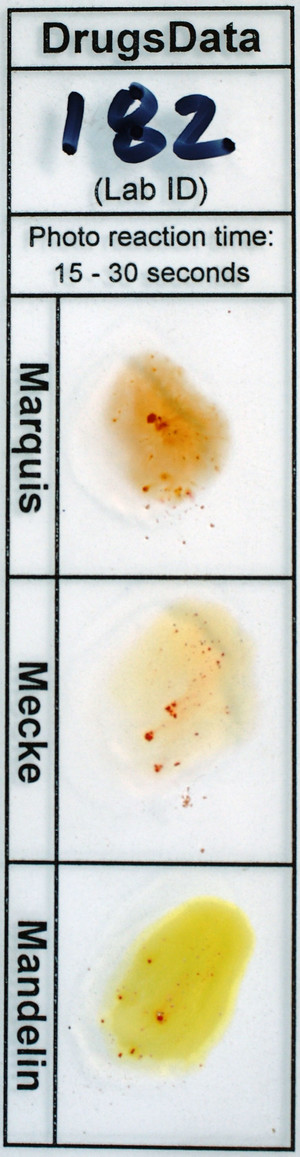
Detail Photo

New Submissions Are Not Currently Being Accepted
Samples sent after April 10, 2024 will be put on hold.
Viewing desktop version: Switch to Mobile
AD 30
Sold as: Adderall 30mg
ID: 11555
Sold as: Adderall 30mg
Expected to be: Adderall 30mg
Has Been Tried: No

Sender comments that sample ''Looks thinner and more orange then other AD30 pills.''